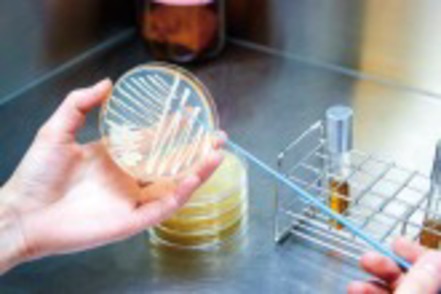
東京農業大学 食の安全・安心を守るために必要な方法やルールを理論的に学びます。（分子微生物学科）

東京農業大学 生命科学部
- 定員数:
- 410人
分子・微生物・動物個体発生や脳機能等、ミクロからマクロまで生命科学を学ぶ
| 学べる学問 |
|
|---|---|
| 目指せる仕事 |
|
| 初年度納入金: | 2025年度納入金(参考) 159万3800円 |
|---|
東京農業大学 生命科学部の募集学科・コース
生命をつなぐ遺伝子の力を解き明かし、未来の生活に貢献。最先端技術を駆使するエキスパートへ
原子・分子の視点から生命、農業、生態系を化学する
微生物が活躍するミクロの世界を先端科学で解明する
東京農業大学 生命科学部のキャンパスライフShot

- 原子・分子から生命・生態系を科学します。(分子生命化学科)

- 「暗記パン」が現実に!? バイオサイエンスで空想の具現化を目指します。(バイオサイエンス学科)
- 食の安全・安心を守るために必要な方法やルールを理論的に学びます。(分子微生物学科)
東京農業大学 生命科学部の学部の特長
生命科学部の学ぶ内容
- バイオサイエンス学科
- 研究のキーワードは遺伝子。遺伝子が生物の体の中でどのように働き、生命をコントロールしているか、遺伝子の持つ未知なるパワーを探り、食料、医療、環境保全など、人類が抱える多くの問題の解決に挑みます。生物学にとどまることなく、医学、薬学、工学に至る応用分野にチャレンジすることで、人類の未来を創造する最先端の研究に取り組んでいきます。
- 分子生命化学科
- 本学科は、「生命の謎を化学で解明し、ファンダメンタルなケミストリーを学ぶ」ことをコンセプトにしています。分子生命化学とは、生命・生態系を化学的に追究する学問です。化学と生物をバランスよく学び、知識を統合することで、生態系のより高度な理解につなげます。3年次からは5つの研究室に分かれ、時代の変化に囚われない普遍的な価値を持つ研究成果の発信と、人材育成をめざします。
- 分子微生物学科
- 微生物は我々の目に見えない世界で活動し、動・植物の健康や地球環境の維持に多大な影響をおよぼしています。しかし人類がこれまでに発見できた微生物はその総数のほんの数%。本学科は「微生物学」に秘められた無限のパワーと可能性を先端科学の力で追究することで、医療や創薬、動・植物の健康、地球環境の維持・保全などの幅広い分野で、未解明の研究テーマにも果敢に挑戦する独創性に富む科学者の育成をめざします。
生命科学部の資格
- 取得できる資格
- 高等学校教諭1種免許状【理科・農業】*、中学校教諭1種免許状【理科】*、司書* 、学芸員* 、食品衛生監視員 (任用資格) 、食品衛生管理者* ※*は国家資格。科目等は学科により異なる
生命科学部の施設・設備
- 生物資源ゲノム解析センター
- 次世代シーケンサー4台を導入し、主に農学分野を対象に遺伝情報を解析。ゲノム研究拠点として重要な役割を果たしています。文部科学大臣認定「特色ある共同利用・共同研究拠点」として、学内外の共同研究も支援しています。
- 外国語研究室
- 英語の総合的な学習と、英語の背景にある文化の理解をめざし、国際交流の場で積極的に意見交換できる教養を養います。
東京農業大学 生命科学部の入試・出願
東京農業大学 生命科学部の目指せる仕事
東京農業大学 生命科学部の就職率・卒業後の進路
■2024年3月卒業生就職実績
東京国税局、神奈川県庁、長野県庁、川崎市役所、日本食品分析センター、江東微生物研究所、社団寿幸会 田園都市レディースクリニック、浅田レディースクリニック、三菱ケミカルグループ、三菱電機、東京電力ホールディングス、昭和産業、中興化成工業、中本パックス、伊藤ハム、山崎製パン、ミヨシ油脂、ANAフーズ、ブルボン、サッポロビール、ジャパンフーズ、カネコ種苗、サカタのタネ、ニトリ、ライフコーポレーション、オーケー、コスモス薬品、サイゼリヤ、ゼンショーホールディングス、富士薬品、日本ステリ、新日本科学PPD、ボゾリサーチセンター、シミック、インテック、富士ソフト、野村マイクロ・サイエンス、東邦システムサイエンス、TOKAIコミュニケーションズ、内田洋行、システナ、シーイーシー、ソフトウェア・サービス、ノバシステム、ジャステック、EP綜合、JALインフォテック、KFCホールディングス、三井住友トラストTAソリューション、メイテックフィルダーズ、ウイルテック、アイヴィス、キャリアデザインセンター、タカミヤ、リベロ、エウレカ社、イーサポートリンク、RYODEN ほか
東京農業大学 生命科学部の問い合わせ先・所在地
〒156-8502 東京都世田谷区桜丘1-1-1
TEL:03-5477-2226
| 所在地 | アクセス | 地図 |
|---|---|---|
| 世田谷キャンパス : 東京都世田谷区桜丘1-1-1 |
「経堂」駅から徒歩 15分 「千歳船橋」駅から徒歩 15分 「用賀」駅から渋谷駅行・祖師ヶ谷大蔵駅行バス 農大前下車 (所要時間10分) |
